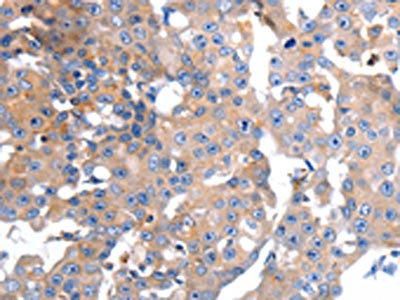

GCG Antibody
-
中文名稱:GCG兔多克隆抗體
-
貨號(hào):CSB-PA160122
-
規(guī)格:¥1100
-
圖片:
-
其他:
產(chǎn)品詳情
-
Uniprot No.:
-
基因名:
-
別名:GCG antibody; Glicentin related polypeptide antibody; glicentin-related polypeptide antibody; GLP-1 antibody; GLP-1(7-36) antibody; GLP-1(7-37) antibody; GLP-2 antibody; GLP1 antibody; GLP1; included antibody; GLP2 antibody; GLP2; included antibody; GLUC_HUMAN antibody; Glucagon antibody; Glucagon like peptide 1 antibody; glucagon-like peptide 1 antibody; Glucagon-like peptide 1; included antibody; Glucagon-like peptide 2 antibody; Glucagon-like peptide 2; included antibody; GRPP antibody; OXM antibody; OXY antibody; preproglucagon antibody
-
宿主:Rabbit
-
反應(yīng)種屬:Human,Mouse,Rat
-
免疫原:Synthetic peptide of Human GCG
-
免疫原種屬:Homo sapiens (Human)
-
標(biāo)記方式:Non-conjugated
-
抗體亞型:IgG
-
純化方式:Antigen affinity purification
-
濃度:It differs from different batches. Please contact us to confirm it.
-
保存緩沖液:-20°C, pH7.4 PBS, 0.05% NaN3, 40% Glycerol
-
產(chǎn)品提供形式:Liquid
-
應(yīng)用范圍:ELISA,IHC
-
推薦稀釋比:
Application Recommended Dilution ELISA 1:1000-1:2000 IHC 1:10-1:50 -
Protocols:
-
儲(chǔ)存條件:Upon receipt, store at -20°C or -80°C. Avoid repeated freeze.
-
貨期:Basically, we can dispatch the products out in 1-3 working days after receiving your orders. Delivery time maybe differs from different purchasing way or location, please kindly consult your local distributors for specific delivery time.
-
用途:For Research Use Only. Not for use in diagnostic or therapeutic procedures.
相關(guān)產(chǎn)品
靶點(diǎn)詳情
-
功能:Plays a key role in glucose metabolism and homeostasis. Regulates blood glucose by increasing gluconeogenesis and decreasing glycolysis. A counterregulatory hormone of insulin, raises plasma glucose levels in response to insulin-induced hypoglycemia. Plays an important role in initiating and maintaining hyperglycemic conditions in diabetes.; Potent stimulator of glucose-dependent insulin release. Also stimulates insulin release in response to IL6. Plays important roles on gastric motility and the suppression of plasma glucagon levels. May be involved in the suppression of satiety and stimulation of glucose disposal in peripheral tissues, independent of the actions of insulin. Has growth-promoting activities on intestinal epithelium. May also regulate the hypothalamic pituitary axis (HPA) via effects on LH, TSH, CRH, oxytocin, and vasopressin secretion. Increases islet mass through stimulation of islet neogenesis and pancreatic beta cell proliferation. Inhibits beta cell apoptosis.; Stimulates intestinal growth and up-regulates villus height in the small intestine, concomitant with increased crypt cell proliferation and decreased enterocyte apoptosis. The gastrointestinal tract, from the stomach to the colon is the principal target for GLP-2 action. Plays a key role in nutrient homeostasis, enhancing nutrient assimilation through enhanced gastrointestinal function, as well as increasing nutrient disposal. Stimulates intestinal glucose transport and decreases mucosal permeability.; Significantly reduces food intake. Inhibits gastric emptying in humans. Suppression of gastric emptying may lead to increased gastric distension, which may contribute to satiety by causing a sensation of fullness.; May modulate gastric acid secretion and the gastro-pyloro-duodenal activity. May play an important role in intestinal mucosal growth in the early period of life.
-
基因功能參考文獻(xiàn):
- GPR119 is the oleoyl-lysophosphatidylinositol receptor that is required for GLP-1 secretion in enteroendocrine cells. PMID: 29883799
- RYGB increased circulating bile acids, ileal Takeda G protein-coupled receptor 5 (TGR5) and mTORC1 signaling activity, as well as GLP-1 production in both mice and human subjects. Inhibition of ileal mTORC1 signaling by rapamycin significantly attenuated the stimulation of bile acid secretion, TGR5 expression and GLP-1 synthesis induced by RYGB in lean and diet-induced obese mice. PMID: 29859856
- Glucagon role in the pathophysiology of type 2 diabetes.[review] PMID: 29024725
- This review summarizes the current knowledge regarding the role of GLP-1 in the protection against oxidative damage and the activation of the Nrf2 signaling pathway. [review] PMID: 29271910
- Study concludes that in healthy subjects, glucagon-like peptide-1 (GLP-1) increases cardiac output acutely due to a GLP-1-induced vasodilation in adipose tissue and skeletal muscle together with an increase in cardiac work. PMID: 28174344
- Chenodeoxycholic acid stimulates glucagon-like peptide-1 secretion in patients after Roux-en-Y gastric bypass. PMID: 28202805
- The results demonstrate that glucagon-like peptide-1 and insulin synergistically and additively activate vagal afferent neurons. PMID: 28624122
- DPP-4 activity and GLP-1total levels were higher in patients with microvascular complications associated with T2DM. Contrary to expectations, no negative correlation was seen between GLP-1 and DDP-4 levels. This result suggests the possible inefficacy of DDP-4 activity as a marker to predict in vivo degradation of endogenous GLP-1. PMID: 29061224
- Data suggest that cAMP acts as amplifier of insulin secretion triggered by Ca2+ elevation in beta-cells; both messengers are also positive modulators of glucagon release from alpha-cells, but in this case cAMP signaling may be the important regulator and Ca2+ signaling has a more permissive role. [REVIEW] PMID: 28466587
- This study provides evidence that, in HepG2 cells, GLP-1 may affect cholesterol homeostasis by regulating the expression of miR-758 and ABCA1. PMID: 29453982
- This study reports the transition dipole strengths and frequencies of the amyloid beta-sheet amide I mode for the aggregated proteins amyloid-beta1-40, calcitonin, alpha-synuclein, and glucagon. PMID: 28851219
- genetic association studies in population in China: Data confirm that an SNP in an intron of SLC47A1 (rs2289669) is associated with hypoglycemic response to metformin in patients with newly diagnosed type 2 diabetes; differential increases in basal GLP1 plasma levels are also related to this SNP. (SLC47A1 = solute carrier family 47 member 1; GLP1 = glucagon-like peptide-1) PMID: 28321905
- GLP-2 augmented BRIN BD11 beta-cell proliferation, but was less efficacious in 1.1B4 cells. These data highlight the involvement of GLP-2 receptor signalling in the adaptations to pancreatic islet cell stress. PMID: 28746825
- Glucagon-like peptide (GLP-2) stimulates cancer myofibroblast proliferation, migration and invasion; GLP-2 acts indirectly on epithelial cells partly via increased Insulin-like growth factor (IGF) expression in myofibroblasts. PMID: 28363795
- Describe model, in which the release of GIP/GLP-1 is stimulated by glucose in the proximal small intestine, and no differences in the secretion dynamics between healthy individuals and patients with T2D are identified after taking differences in glucose profiles into account. PMID: 28374974
- the solvent exposure of the two Phe sites along the glucagon sequence was determined, showing that 4F-Phe6 was fully solvent exposed and 4F-Phe22 was only partially exposed PMID: 28508109
- Data suggest that dose/intensity-response relationships exist between exercise intensity and total plasma PYY levels, though the effects on total plasma GLP1 levels and hunger perceptions seem unclear. (PYY = peptide YY ; GLP1 = glucagon-like peptide 1) PMID: 27721013
- GLP-2 could be considered an hormone causing positive energy balance, which, however has the role to mitigate the metabolic dysfunctions associated with hyper-adiposity. [review] PMID: 27664588
- Studies indicate that nutrient-induced glucagonlike peptide-1 (GLP-1) response was one of the best predictors of type 2 diabetes mellitus (T2DM) remission after Roux-en-Y-gastric-bypass (RYGB). PMID: 29040429
- Insulin resistance in non-diabetic individuals is associated with raised fasting GLP-1 levels but reduced GLP-1 responses to meal stimulation. PMID: 29097626
- Age-dependent human beta cell proliferation induced by glucagon-like peptide 1 and calcineurin signaling PMID: 28920919
- Data suggest early peaks in glucagon-like peptide-1 and glucagon secretion/blood level together trigger exaggerated insulinotropic response (high insulin secretion/level) to eating and consequent hypoglycaemia in patients with postprandial hypoglycaemia as a postoperative complication following Roux-en-Y gastric bypass for obesity complicated by type 2 diabetes; this retrospective cohort study was conducted in London. PMID: 28855269
- A common variant, i.e., single nucleotide polymorphism rs6741949, in the DPP4 gene interacts with body adiposity and negatively affects glucose-stimulated GLP-1 levels, insulin secretion, and glucose tolerance. PMID: 28750074
- Compared with the lean group, the obese group had significantly higher fasting and post-OGTT GIP levels, but similar fasting GLP-1 and significantly lower post-OGTT GLP-1 levels. PMID: 28655715
- Hemodialysis improves upper GI symptoms and gastric slow waves in CKD patients. An increase in ghrelin and a decrease in GLP-1 might be involved in the HD-induced improvement in gastric slow waves. PMID: 28566304
- Data suggest that, in obesity, serum levels of active GLP1 are down-regulated and serum levels of soluble DPP4 are up-regulated; DPP4 levels correlate negatively with active GLP-1 levels but are positively associated with insulin resistance; thus, DPP4 may be biomarker for insulin resistance. This study was conducted in Malaysia. (GLP1 = glucagon-like peptide 1; DPP4 = dipeptidyl peptidase 4) PMID: 28288852
- Insulin resistance, postprandial GLP-1 and adaptive immunity are the main predictors of NAFLD in a homogeneous population at high cardiovascular risk. PMID: 27134062
- Data suggest that laparoscopic sleeve gastrectomy (LSG) for morbid obesity improves insulin resistance after either fast or slow feeding/eating; these findings suggest a negligible contribution of anorexigenic gut peptides GLP1 (glucagon-like peptide 1) and PYY (peptide YY) from intestinal L cells in response to LSG-induced weight loss. PMID: 27022941
- L-trp is a luminal regulator of CCK release with effects on gastric emptying, an effect that could be mediated by CCK. L-trp's effect on GLP-1 secretion is only minor. At the doses given, the two amino acids did not affect subjective appetite feelings. PMID: 27875537
- rs12104705 CC genotype associated with both general obesity and abdominal obesity in case of new-onset diabetes PMID: 27998387
- The effects of GLP-1-based therapies on blood glucose in type 2 diabetics are not mediated through microvascular responses. PMID: 27562916
- Endogenous GLP1 is involved in the central regulation of feeding by affecting central responsiveness to palatable food consumption. PMID: 26769912
- secretion of oxyntomodulin in patients with type 2 diabetes is significantly impaired. PMID: 27322465
- Glucagon-like Peptide-1 Analogues Inhibit Proliferation and Increase Apoptosis of Human Prostate Cancer Cells PMID: 28008585
- The GLP-1 secretion after 75 g OGTT was impaired in newly diagnosed T2DM patients, inversely proportional to insulin resistance and hyperglycemia, and positively correlated with beta-cell function and insulin sensitivity. PMID: 26739974
- GLP-1 secretion increased in response to inflammatory stimuli in humans, which was associated to parameters of glucose metabolism and best predicted by IL6. PMID: 26842302
- Among young and healthy adults, GLP-1 levels are strongly and independently related to body fat mass especially in men, but not body mass index or waist circumference. PMID: 25865948
- Glucagon circulates in patients without a pancreas and glucose stimulation of the gastrointestinal tract elicits significant hyperglucagonemia in these patients. PMID: 26672094
- There is minor contribution of endogenous GLP-1 and GLP-2 to postprandial lipemia in obese men. PMID: 26752550
- Data suggest that endocrine responses differ between jejunal and gastric enteral feeding, with higher peak plasma CCK (cholecystokinin), PYY (peptide YY), and GLP-1/2 (glucagon-like peptides 1/2) concentrations being attained after jejunal feeding. PMID: 26762368
- Data suggest that capsaicin, an appetite suppressant dietary supplement (here, administered via intraduodenal infusion), does not act via alteration of secretion of satiety hormones GLP-1 (GLP-1) and PYY (peptide YY). PMID: 26718419
- Data show that NCI-H716 cells were immunostained for tumor necrosis factor receptor TNFR1, and TNFalpha treatment enhances glucagon-like peptide-1 (GLP-1) secretion. PMID: 26270730
- active GLP-1 produced in the islet stimulates cholecystokinin production and secretion in a paracrine manner via cyclic AMP and CREB. PMID: 25984632
- Data suggest that secretion of insulin and glucagon is up-regulated in subjects with type 2 diabetes with dyssomnia as compared to subjects with type 2 diabetes without dyssomnia; those with dyssomnia exhibit prehypertension and insulin resistance. PMID: 25957006
- no association of single nucleotide polymorphisms and type 2 diabetes mellitus susceptibility in Chinese population PMID: 25863010
- Data suggest plasma GLP1 (glucagon-like peptide 1) and PYY (peptide YY) can be regulated by digestion-resistant diet factors; intake of soluble dietary fiber (prebiotic Fibersol-2) in a tea with meal up-regulated plasma GLP1/PYY and decreased hunger. PMID: 25823991
- Glucagon has emerged as a key hormone for the regulation of glucose homeostasis and for development of type 2 diabetes. [Review] PMID: 25814364
- The PKC-dependent effect of GLP-1 on membrane potential and electrical activity was mediated by activation of Na(+)-permeable TRPM4 and TRPM5 channels by mobilization of intracellular Ca(2+) from thapsigargin-sensitive Ca(2+) stores PMID: 26571400
- The actions of GLP-2 are transduced by the GLP-2 receptor [GLP-2R], which is localized in the neurons of the enteric nervous system but not in the intestinal epithelium. PMID: 25218018
- GLP-1 increases PGC-1(alpha) expression by downregulating miR-23a in liver cells. PMID: 26315270
顯示更多
收起更多
-
亞細(xì)胞定位:Secreted.; [Glucagon-like peptide 1]: Secreted.
-
蛋白家族:Glucagon family
-
組織特異性:[Glucagon]: Secreted in the A cells of the islets of Langerhans.; [Glucagon-like peptide 1]: Secreted in the A cells of the islets of Langerhans. Secreted from enteroendocrine L cells throughout the gastrointestinal tract. Also secreted in selected neuron
-
數(shù)據(jù)庫鏈接:
Most popular with customers
-
-
YWHAB Recombinant Monoclonal Antibody
Applications: ELISA, WB, IHC, IF, FC
Species Reactivity: Human, Mouse, Rat
-
Phospho-YAP1 (S127) Recombinant Monoclonal Antibody
Applications: ELISA, WB, IHC
Species Reactivity: Human
-
-
-
-
-